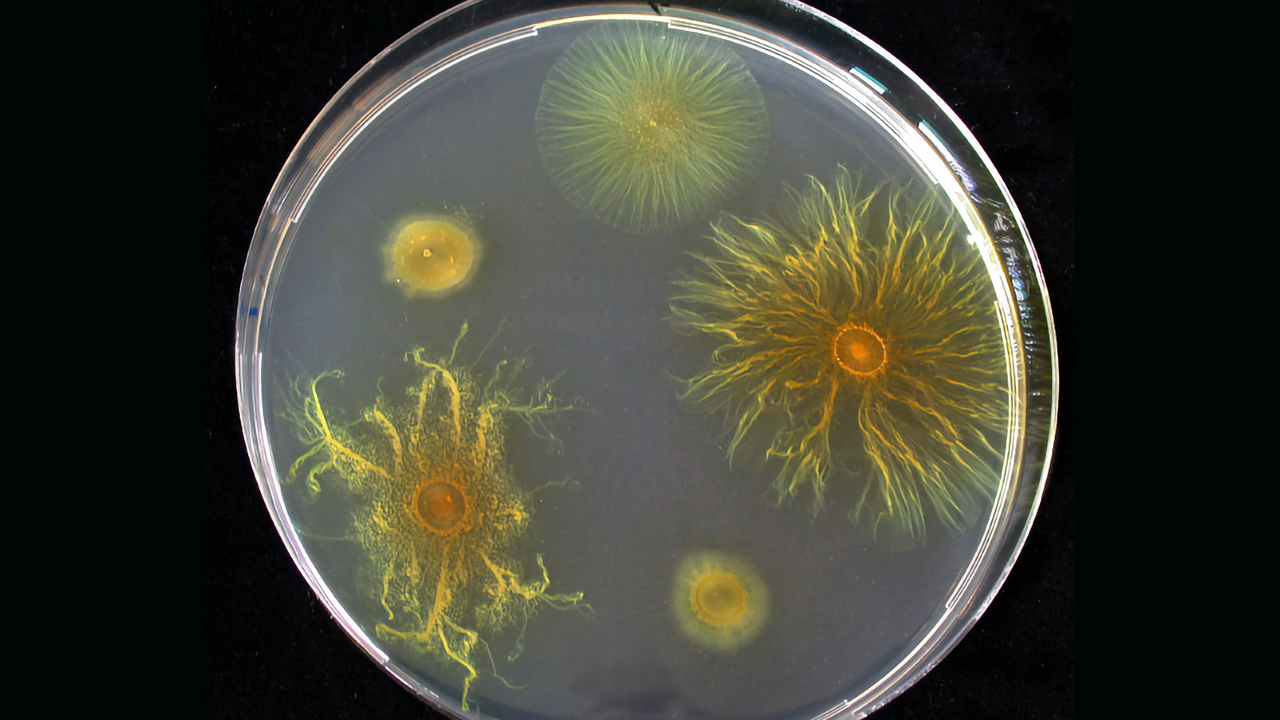

The team found that certain types of bacteria can multiply inside tumors, making them a useful target for treatment. The approach involves using probiotic strains of E. coli that break down when they enter the tumor and release their contents to attack cancer cells.
At the same time, bacteria successfully survive only in the unique environment of the tumor, so the risk of spreading bacteria to other organs is minimal.
The scientists confirmed the effectiveness of their technique in experiments on mice. It was able to elicit a sustained immune response against tumors both near and far. This suggests that a drug containing regulated bacteria could be administered intravenously.
It has been reported that a patent application has been filed for the new method. In addition, experts are actively researching to optimize treatment for further clinical trials.
Source: Ferra
I am a professional journalist and content creator with extensive experience writing for news websites. I currently work as an author at Gadget Onus, where I specialize in covering hot news topics. My written pieces have been published on some of the biggest media outlets around the world, including The Guardian and BBC News.